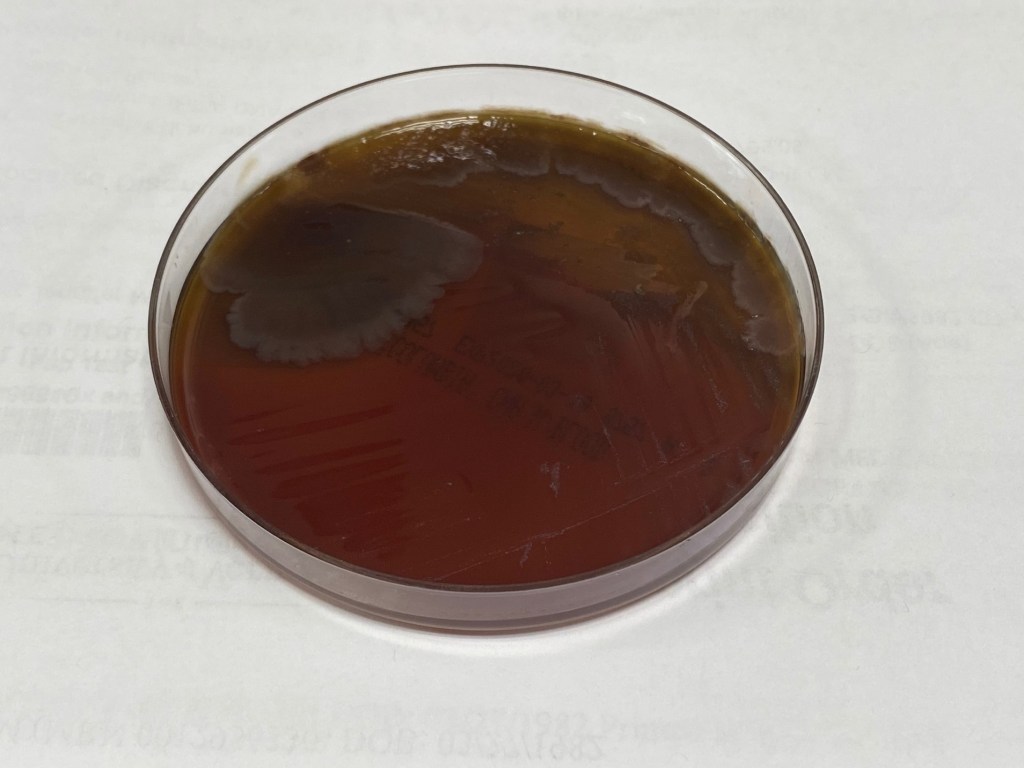
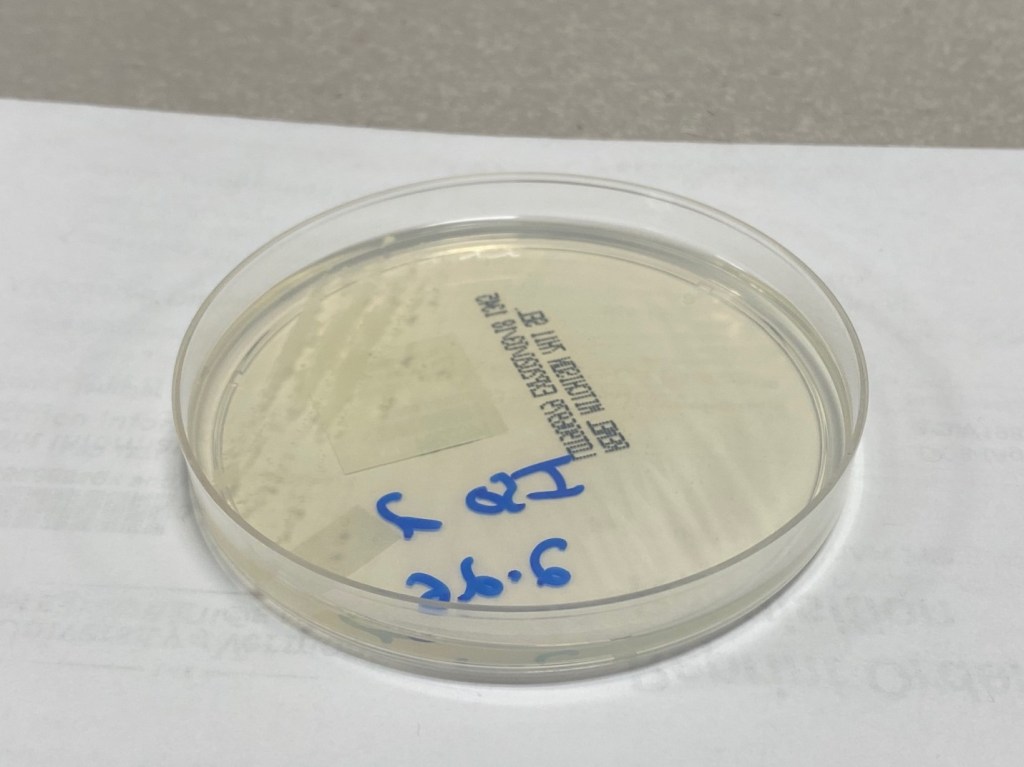

Case History
A 29 year old African American male presented to the emergency department for a 3 day history of fever, chills, and night sweats, approximately four weeks after returning home from a trip to Uganda. He denied any diarrhea, vomiting, cough, abdominal pain, nausea, or sick contacts. His past medical history was non-contributory. A complete blood count (CBC) was performed, which revealed anemia and low platelets. The patient’s blood was also analyzed through Giemsa stain on a thin smear preparation (Image 1). Findings revealed only several platelets present. In addition, the patient’s red blood cell morphology was varied and atypical. The cells appear smaller than normal (microcytic) with several shapes and form being present: acanthocytes (burr cells), schistocytes (fragmented red blood cells), and bite cells (red blood cells which appear as if a “bite” has been taken out of them). In addition, many red blood cells contained a delicate ring form with either a central chromatin dot or two dots in a “headphone” arrangement (Image 2). This ring form was the only form identified in the thin smear. In addition, it was only present inside the red blood cells (with no forms present outside the cells) and the red blood cells with the ring form were the same size as those blood cells without the ring form. Finally, several red blood cells were seen occupied by more than one ring form. A thick smear of the patient’s blood was prepared in order to lyse the red blood cells so that the cellular contents could be analyzed with increased sensitivity. Findings on the thick smear revealed the similar delicate ring form structure found inside the red blood cells on the thin smear. These were the only forms identified and they also contained either a central chromatin dot or two bi-lobed dots (“headphone” forms) (Image 3).



Diagnosis
The main differential diagnoses of ring forms present in red blood cells include two parasitic organisms: Babesia and Plasmodium species. Endemic regions for Babesia include the Midwest and Eastern United States, the majority of Europe, and parts of central Asia and Far East Asia. In addition, the ring forms of Babesia are pleomorphic (varying in size and shape from cell-to-cell) with rare distinctive “Maltese cross” forms (indicative of asexual budding).
Plasmodium, on the other hand, is endemic to South America, most of Sub-Saharan Africa (including Uganda), and parts of Asia (such as India, Southern China, and Indonesia). The most common Plasmodium sub-species in Uganda is P. falciparum, which accounts for over 90% of Plasmodium cases. The ring forms of Plasmodium are monomorphic. Considering the patient’s travel history, as well as the findings on the thin smear and thick smear of the patient’s blood, the organism was confirmed as Plasmodium falciparum through polymerase chain reaction (PCR).
Discussion
Malaria is caused by the single-cell parasitic protozoan Plasmodium species, which is transmitted through an arthropod vector (Anopheles mosquito). Approximately 40% of the world’s population lives in endemic areas, 300-500 million clinical cases occur world-wide per year, resulting in 1.5-2.7 million deaths (90% of which are in Africa). However, this is an increasing problem even in non-endemic areas, considering the ease and flexibility of international travel, vague generalized clinical symptoms which could cause a delay in diagnosis, and drug resistance to the main active agents against the protozoan.
The Anopheles mosquito injects a sporozoite form of the parasite into humans, which then penetrates liver cells and matures into a schizont. The schizont then breaks through the liver cell and enters the blood stream as a merozoite, which invades red blood cells. The trophozoite form then matures in the red blood cells (as a “ring form”), which then re-enters the blood stream as a merozoite form. Finally, the merozoite matures into macrogametocytes and microgametocytes, which are taken up by the Anopheles mosquito.
The onset of symptoms usually occurs within 1 month (for patients that are not endemic to the region) or up to 6 months (for patients who have lived in Plasmodium regions and have presumably developed some sort of an immune tolerance to the parasite). These symptoms are characterized as “paroxysmal” and “cyclical,” which include chills, fever, sweats, and resolution, followed by another cycle of symptoms. Studies have shown that symptoms correlate with the release of merozoites into the blood stream, causing tissue necrosis factor release from circulating white blood cells. Patients may also develop anemia, splenomegaly, and acute renal failure. A unique complication of P. falciparum is its ability to infect a large number of mature red blood cells, rather than only young red blood cells. This results in high levels of parasitemia and increased clumping of red blood cells due to the induction of proteins in the cell that cause agglutination to other cells. This may result in “cerebral” malaria, which may cause altered mental status, coma, or even death.
References:
- Laboratory diagnosis of malaria: Plasmodium falciparum. CDC Laboratory Identification of Parasites of Public Health Concern. https://www.cdc.gov/dpdx/resources/pdf/benchAids/malaria/Pfalciparum_benchaidV2.pdf
- Kerlin, Douglas and Gatton, Michelle. Preferential Invasion by Plasmodium Merozoites and the Self-Regulation of Parasite Burden. Public Library of Science. 2013; 8(2): e57434. https://www.ncbi.nlm.nih.gov/pmc/articles/PMC3584029/
–Jamaal Rehman, MD is a 4th year anatomic and clinical pathology resident at University of Chicago (NorthShore) program based at Evanston Hospital, Evanston, IL. His academic interests include Surgical pathology, specifically Gastrointestinal pathology. He will be matriculating to the University of Iowa for a Gastrointestinal pathology fellowship following residency training.

-Erin McElvania, PhD, D(ABMM), is the Director of Clinical Microbiology NorthShore University Health System in Evanston, Illinois. Follow Dr. McElvania on twitter @E-McElvania.